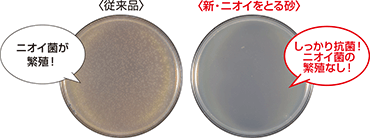

24時間ニオイ菌をパワフル抗菌、1日中ず~っと消臭!
「ニオイをとる砂」がさらにパワーアップしました。 新消臭成分(ALM)の配合で抗菌力を強化し、時間が経ったネコちゃんのオシッコ臭を強力に防ぎます。 独自の「香りのハーモナイズド技術」で爽快消臭!
ハーモナイズド技術とは、香りと悪臭をうまく調和させて、悪臭を別の香りに変化させること。オシッコやうんちのニオイを、爽やかな香りに変えて消臭します。
猫の習性を徹底的に研究して開発されました!新消臭成分「ポリフェノール」の働きで、オシッコやフンのニオイを元から消臭!
時間とともに発生するアルカリ性の嫌なオシッコのニオイを銀・銅の作用により強力に消臭!大腸菌などのバイキンに対しても強力な抗菌効果を発揮します。
ガッチリ固まる鉱物製の猫砂。消臭・抗菌力がパワーアップ。
粉が舞いにくいので、お部屋が清潔に保てます。
ニオイをとる砂-機能

ハーモナイズド技術とは、香りと悪臭をうまく調和させて、悪臭を別の香りに変化させること。 オシッコやうんちのニオイを、爽やかな香りに変えて消臭します。


トイレのニオイの経時変化
抗菌力テスト(24時間後)
商品詳細
- 成分
- ベントナイト、ポリフェノール、銅系消臭剤、銀系抗菌剤
- 内容量
- 5L×4袋
- 製造
- 日本
- 使用後、固まった部分は少量ずつ可燃ゴミとして処理してください。 (ただしお住まいの自治会の指導がある場合にはそれに従ってください。) つまりの原因になりますので水洗トイレ・排水口には流さないで下さい。





